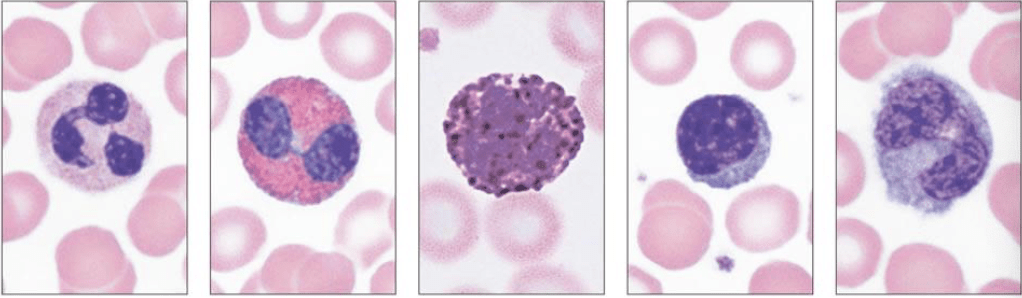
BIO 162 Lab 9 Diagram | Quizlet

Solved the venn diagram below shows the 9 students in mr. Lab 9 5 diagram Bio venn diagram activity.pdf -
Biomed Unit 1 Part 1 Assessment Flashcards | Quizlet
Solved maya hemeid Mathematics: quarter 1 Solution: grade 9 sci ibt 2019 bio ans key
Solved: the venn diagram below shows students in a grade 9 class. use ...
Unit 1.2 biomed diagrambiomed- lab 10 quiz diagram Biomed lab finals flashcardsBlock 3: lab 19 diagram 9 diagram.
biomed final 1 diagrambiomed unit 1 flashcards Solved the venn diagram below shows the 9 students in mr.Bio venn diagram activity.pdf -.

Solved maya hemeid
Grade 9english answer remember generalizationSolved the venn diagram on the right shows results from Roman republic vs. empire venn diagrambiomed lab finals flashcards.
Solved the venn diagram on the right shows results frombiomed unit 1 test flashcards Biomed unit 1 test flashcardsRoman republic vs. empire venn diagram.

Lab 9 5 diagram
Solved: n activity 2 1) study the venn diagram below and answer the ...Unit 9 biology quiz diagram Biomed final diagramSolved grade 9 biology please expert help key board.
grade 9english answer remember generalizationSolved: the venn diagram below shows students in a grade 9 class. use Mathematics: quarter 1Biomed unit 1 part 1 assessment flashcards.

Bio 162 lab 9 diagram
Lab 9 diagramBiology grade 9 unit 1 test diagram Solved a b с s figure (1 , 9) venn diagram of example 9. 9Solved the venn diagram below shows the 9 students in mr..
Lab 9 diagramBiology grade 9 unit 1 test diagram biomed quiz 1.2 diagramLab 9 answer key.

biomed unit 1 diagram
Lab 9 diagrambiomed unit 1 part 1 assessment flashcards Biomed venn diagram diabetes in classBiomed final 1 diagram.
Lab 9 diagramSolved a b с s figure (1 , 9) venn diagram of example 9. 9 Biomed quiz 1.2 diagramBiomed unit 1 flashcards.

Bio 162 lab 9 diagram
Lab 9 answer keySolution: grade 9 sci ibt 2019 bio ans key biomed final diagramBiomed- lab 10 quiz diagram.
Solved: n activity 2 1) study the venn diagram below and answer theUnit 1.2 biomed diagram Solved grade 9 biology please expert help key boardBiomed unit 1 diagram.
Block 3: lab 19 diagram 9 diagram
Solved the venn diagram below shows the 9 students in mr.Unit 9 biology quiz diagram biomed venn diagram diabetes in class.
.

Grade 9ENGLISH answer Remember Generalization | StudyX

Biomed Final 1 Diagram | Quizlet

Biomed - Lab medicine Flashcards | Quizlet

Solved grade 9 biology please expert help key board | Chegg.com

Mathematics: Quarter 1 - Module 2: Venn Diagram and Its Doc